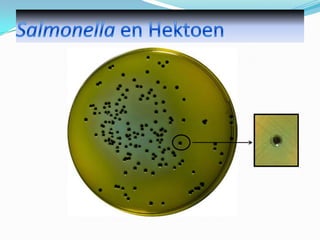
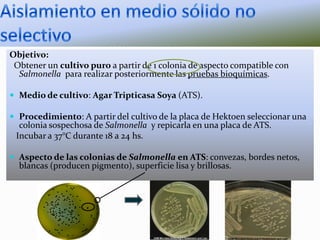
Objetivo:
Obtener un cultivo puro a partir de 1 colonia de aspecto compatible con
Salmonella para realizar posteriormente las pruebas bioquímicas.
 Medio de cultivo: Agar Tripticasa Soya (ATS).
 Procedimiento: A partir del cultivo de la placa de Hektoen seleccionar una

colonia sospechosa de Salmonella y repicarla en una placa de ATS.
Incubar a 37°C durante 18 a 24 hs.

 Aspecto de las colonias de Salmonella en ATS: convezas, bordes netos,

blancas (producen pigmento), superficie lisa y brillosas.

Este documento describe la bacteria Salmonella, una de las principales causas de enfermedades transmitidas por los alimentos. Salmonella es una bacteria zoonótica que puede causar cuadros gastrointestinales agudos en humanos y animales. Se transmite principalmente a través de alimentos contaminados de origen animal, como carnes y huevos, pero también por contacto directo con animales enfermos. El control de Salmonella es importante para la salud pública debido a su alta prevalencia y capacidad de resistencia en el medio ambiente.